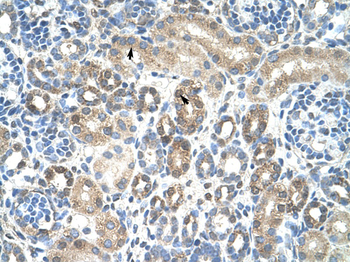
CAV1 Rabbit Polyclonal Antibody

You have no items in your shopping cart.
Search results for: 'CAV1'
- Caveolin-1 Recombinant Rabbit Monoclonal Antibody [orb1816721]Featured

IF, IHC-Fr, IHC-P
Human
Rabbit
Recombinant
Unconjugated
25 μl, 100 μl, 50 μl - CAV1 Rabbit Polyclonal Antibody [orb592746]
IHC, WB
Human
Bovine, Canine, Equine, Mouse, Porcine, Rabbit, Rat, Sheep
Rabbit
Polyclonal
Unconjugated
100 μl - Caveolin-1/CAV1 Antibody [orb47981]
FC, IF, IHC, WB
Human, Mouse, Rat
Rabbit
Polyclonal
Unconjugated
100 μg - Goat anti-Caveolin 1, Biotinylated Antibody [orb389360]
ELISA, ICC, WB
Human
Goat
Polyclonal
Unconjugated
100 μg - Cav1.3 Antibody: Biotin [orb148178]Featured

ELISA, ICC, IF, IHC, WB
Human, Mouse, Rat
Mouse
Monoclonal
Biotin
100 μg - Cav1.3 Antibody: PerCP [orb148182]Featured

ELISA, ICC, IF, IHC, WB
Human, Mouse, Rat
Mouse
Monoclonal
PerCP
100 μg